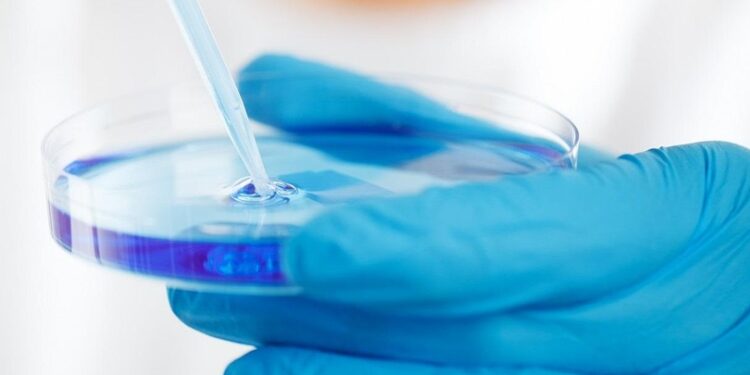
Sexto sentido do corpo humano está perto de ser oficializado por cientistas

Pesquisadores do Scripps Research e do Instituto Allen, nos Estados Unidos, receberam o Prêmio de Pesquisa Transformadora dos Institutos Nacionais de Saúde (NIH) para criar o primeiro atlas da interocepção, rede neural descrita como o “sexto sentido oculto” do corpo humano.
O projeto, liderado pelo neurocientista Ardem Patapoutian, vencedor do Prêmio Nobel de 2021 por suas descobertas sobre sensores celulares do toque, contará com US$ 14,2 milhões (cerca de R$ 78,2 milhões) em financiamento ao longo de cinco anos.
A interocepção é o sistema responsável por monitorar e regular as funções internas do corpo, como respiração, circulação, digestão e temperatura corporal, além de permitir que o cérebro perceba sensações como fome, sede, frio ou batimentos cardíacos acelerados. Diferentemente dos sentidos tradicionais, como visão, olfato e audição, ela atua por meio de vias neurais internas que conectam órgãos e cérebro.
Segundo Patapoutian, o estudo busca mapear em 3D como os neurônios sensoriais se ligam aos órgãos e identificar geneticamente os diferentes tipos de células envolvidas nesse processo. “A interocepção é fundamental para quase todos os aspectos da saúde, mas ainda é uma fronteira largamente inexplorada da neurociência”, afirmou o pesquisador.
Os cientistas esperam que o atlas ajude a compreender melhor a comunicação corpo-cérebro e leve a novas abordagens terapêuticas para doenças como dor crônica, distúrbios autoimunes, hipertensão e neurodegeneração, todas associadas à desregulação dessas vias.
“Ao decodificar a interocepção, queremos entender como o cérebro mantém o corpo em equilíbrio e como restaurar esse equilíbrio quando ele é perdido”, explicou Xin Jin, professor do Scripps Research e um dos líderes do projeto, em nota.